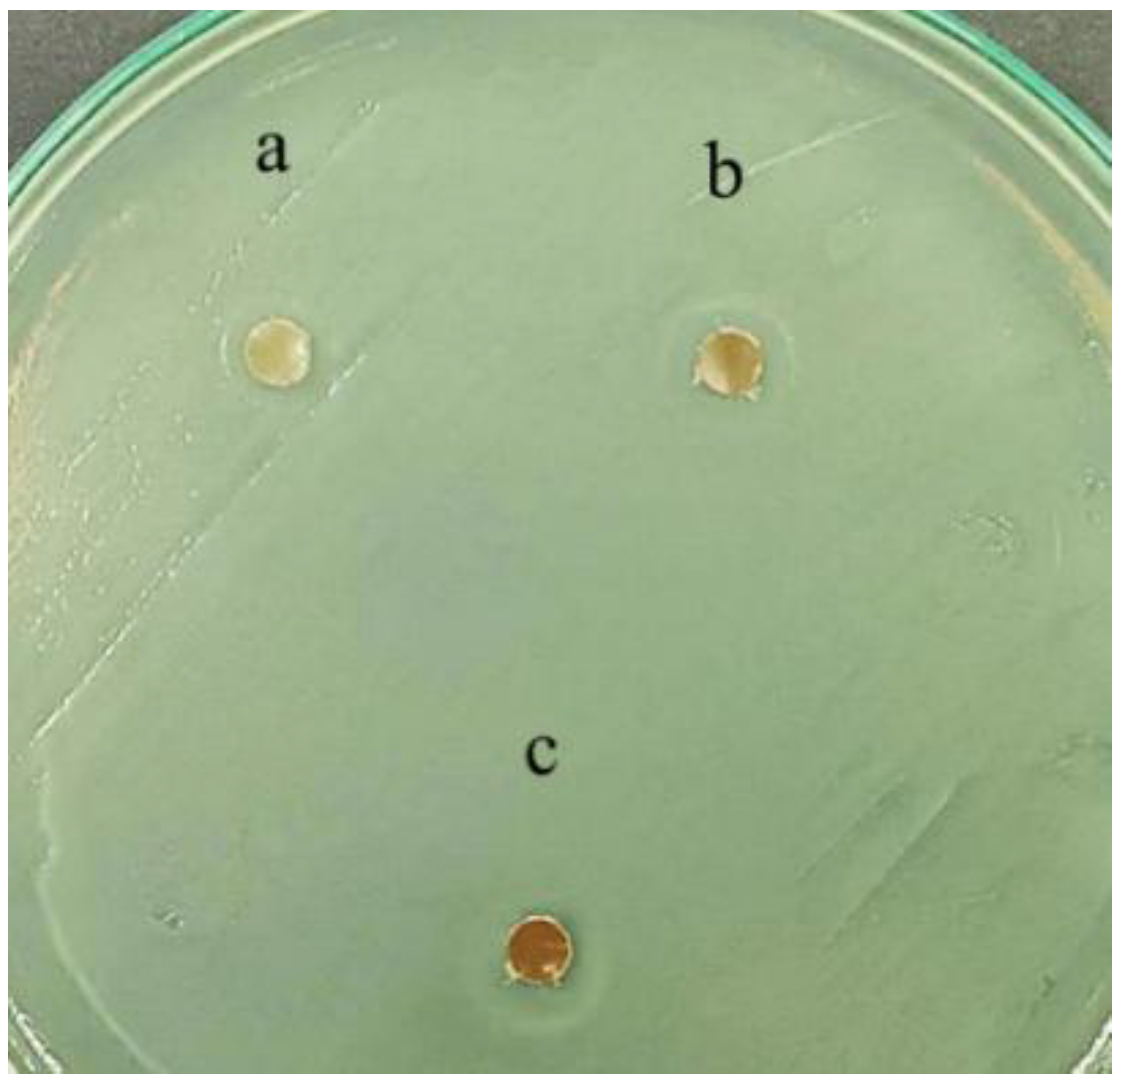
Polymers 17 01345 g006

Biocompatible, Biodegradable, and Antimicrobial Food Packaging Film from Polylactic Acid and Biogenic Vaterite CaCO3-Ag Hybrid
Abstract
1. Introduction
2. Experimental Details
2.1. Materials
2.2. Micro-Compounding and Moulding Process
2.3. Characterization
2.3.1. Scanning Electron Microscopy (SEM) and Energy Dispersive X-Ray Spectroscopy (EDS)
2.3.2. X-Ray Diffraction (XRD)
2.3.3. Attenuated Total Reflection Infrared Spectroscopy (ATR-FTIR)
2.3.4. Synchrotron X-Ray Absorption Spectroscopy (XAS)
2.3.5. Thermogravimetric Analysis (TGA) and Differential Scanning Calorimetry (DSC)
2.3.6. Universal Test
2.3.7. Nanoindentation
2.3.8. Cell Cytotoxicity Assay
2.3.9. Disk-Diffusion Susceptibility Test
2.3.10. Minimum Inhibitory Concentration (MIC) Assay
2.3.11. WVTR and OTR
3. Results and Discussion
3.1. Morphology Study
3.2. Structural Study
3.3. Synchrotron X-Ray Absorption Spectroscopy (XAS)
3.4. Cell Viability
3.5. Antimicrobial Test
3.6. Macromechanical and Nanomechanical Properties
3.7. Thermal Properties
3.8. OTR and WVTR
4. Conclusions
Author Contributions
Funding
Institutional Review Board Statement
Data Availability Statement
Acknowledgments
Conflicts of Interest
References
- Fahmy, H.M.; Eldin, R.E.S.; Serea, E.S.A.; Gomaa, N.M.; AboElmagd, G.M.; Salem, S.A.; Shalan, A.E. Advances in nanotechnology and antibacterial properties of biodegradable food packaging materials. RSC Adv. 2020, 10, 20467–20484. [Google Scholar] [CrossRef] [PubMed]
- Priyanka, S.; Namasivayam, K.R.; Bharani, A.R.S.; Arun, J. Biocompatible green technology principles for the fabrication of food packaging material with noteworthy mechanical and antimicrobial properties—A sustainable developmental goal towards the effective, safe food preservation strategy. Chemosphere 2023, 336, 139240. [Google Scholar] [CrossRef]
- Chausali, N.; Saxena, J.; Prasad, R. Recent trends in nanotechnology applications of bio-based packaging. J. Agric. Food Res. 2022, 7, 100257. [Google Scholar] [CrossRef]
- Cheng, J.; Gao, R.; Zhu, Y.; Lin, Q. Applications of biodegradable materials in food packaging: A review. Alex. Eng. J. 2024, 91, 70–83. [Google Scholar] [CrossRef]
- Skorokhoda, V.; Semeniuk, I.; Peretyatko, T.; Kochubei, V.; Ivanukh, O.; Melnyk, Y.; Stetsyshyn, Y. Biodegradation of Polyhydroxybutyrate, Polylactide, and Their Blends by Microorganisms, Including Antarctic Species: Insights from Weight Loss, XRD, and Thermal Studies. Polymers 2025, 17, 675. [Google Scholar] [CrossRef]
- Yang, S.; Shang, P.; Zhang, K.; Wang, J.; Zhang, B.; Gao, X.; Xu, J. PBAT/PLA food packaging film containing sodium dehydroacetate-loaded diatomite as an antibacterial agent: Fabrication, water-gas regulation and long-acting antimicrobial mechanism. Food Chem. 2024, 446, 138880. [Google Scholar] [CrossRef]
- Ordoñez, R.; Atarés, L.; Chiralt, A. Multilayer antimicrobial films based on starch and PLA with superficially incorporated ferulic or cinnamic acids for active food packaging purposes. Food Chem. Adv. 2023, 2, 100250. [Google Scholar] [CrossRef]
- Cheng, J.; Lin, X.; Wu, X.; Liu, Q.; Wan, S.; Zhang, Y. Preparation of a multifunctional silver nanoparticles polylactic acid food packaging film using mango peel extract. Int. J. Biol. Macromol. 2021, 188, 678–688. [Google Scholar] [CrossRef]
- Kim, I.; Viswanathan, K.; Kasi, G.; Thanakkasaranee, S.; Sadeghi, K.; Seo, J. ZnO Nanostructures in Active Antibacterial Food Packaging: Preparation Methods, Antimicrobial Mechanisms, Safety Issues, Future Prospects, and Challenges. Food Rev. Int. 2022, 38, 537–565. [Google Scholar] [CrossRef]
- Zhang, R.; Lan, W.; Ji, T.; Sameen, D.E.; Ahmed, S.; Qin, W.; Liu, Y. Development of polylactic acid/ZnO composite membranes prepared by ultrasonication and electrospinning for food packaging. LWT 2021, 135, 110072. [Google Scholar] [CrossRef]
- Marra, A.; Silvestre, C.; Duraccio, D.; Cimmino, S. Polylactic acid/zinc oxide biocomposite films for food packaging application. Int. J. Biol. Macromol. 2016, 88, 254–262. [Google Scholar] [CrossRef] [PubMed]
- Rojas, A.; Misic, D.; de Dicastillo, C.L.; Zizovic, I.; Velásquez, E.; Gutiérrez, D.; Galotto, M.J. A review on thymol-based bioactive materials for food packaging. Ind. Crops Prod. 2023, 202, 116977. [Google Scholar] [CrossRef]
- Gonon, H.; Srisa, A.; Promhuad, K.; Chonhenchob, V.; Bumbudsanpharoke, N.; Jarupan, L.; Harnkarnsujarit, N. PLA thermoformed trays incorporated with cinnamaldehyde and carvacrol as active biodegradable bakery packaging. Food Packag. Shelf Life 2023, 38, 101123. [Google Scholar] [CrossRef]
- Roy, S.; Rhim, J.-W. Preparation of bioactive functional poly(lactic acid)/curcumin composite film for food packaging application. Int. J. Biol. Macromol. 2020, 162, 1780–1789. [Google Scholar] [CrossRef]
- Jin, T.; Zhang, H. Biodegradable Polylactic Acid Polymer with Nisin for Use in Antimicrobial Food Packaging. J. Food Sci. 2008, 73, M127–M134. [Google Scholar] [CrossRef]
- Zhang, W.; Huang, C.; Kusmartseva, O.; Thomas, N.L.; Mele, E. Electrospinning of polylactic acid fibres containing tea tree and manuka oil. React. Funct. Polym. 2017, 117, 106–111. [Google Scholar] [CrossRef]
- Kayaci, F.; Umu, O.C.O.; Tekinay, T.; Uyar, T. Antibacterial Electrospun Poly(lactic acid) (PLA) Nanofibrous Webs Incorporating Triclosan/Cyclodextrin Inclusion Complexes. J. Agric. Food Chem. 2013, 61, 3901–3908. [Google Scholar] [CrossRef]
- Chiloeches, A.; Cuervo-Rodríguez, R.; Gil-Romero, Y.; Fernández-García, M.; Echeverría, C.; Muñoz-Bonilla, A. Electrospun Polylactic Acid-Based Fibers Loaded with Multifunctional Antibacterial Biobased Polymers. ACS Appl. Polym. Mater. 2022, 4, 6543–6552. [Google Scholar] [CrossRef]
- Walczak, M.; Richert, A.; Burkowska-But, A. The effect of polyhexamethylene guanidine hydrochloride (PHMG) derivatives introduced into polylactide (PLA) on the activity of bacterial enzymes. J. Ind. Microbiol. Biotechnol. 2014, 41, 1719–1724. [Google Scholar] [CrossRef]
- Azarian, M.H.; Sutapun, W. Biogenic calcium carbonate derived from waste shells for advanced material applications: A review. Front. Mater. 2022, 9, 1024977. [Google Scholar] [CrossRef]
- Azarian, M.H.; Sutapun, W. Tuning polymorphs of precipitated calcium carbonate from discarded eggshells: Effects of polyelectrolyte and salt concentration. RSC Adv. 2022, 12, 14729–14739. [Google Scholar] [CrossRef] [PubMed]
- Ferreira, A.M.; Vikulina, A.S.; Bowker, L.; Hunt, J.A.; Loughlin, M.; Puddu, V.; Volodkin, D. Nanoarchitectonics of Bactericidal Coatings Based on CaCO 3 –Nanosilver Hybrids. ACS Appl. Bio Mater. 2024, 7, 2872–2886. [Google Scholar] [CrossRef] [PubMed]
- Azarian, M.H.; Junyusen, T.; Sutapun, W. Tailoring microstructure of superabsorbent film for active food packaging using carboxy methyl cellulose and biogenic vaterite CaCO3–Ag hybrid microspheres. J. Food Eng. 2024, 369, 111938. [Google Scholar] [CrossRef]
- Azarian, M.H.; Junyusen, T.; Sutapun, W. Biogenic Vaterite Calcium Carbonate-Silver/Poly(Vinyl Alcohol) Film for Wound Dressing. ACS Omega 2024, 9, 955–969. [Google Scholar] [CrossRef]
- Mahmood, W.A.K.; Azarian, M.H.; Fathilah, W.F.B.W.; Kwok, E. Nanoencapsulation of montmorillonite clay within poly(ethylene glycol) nanobeads by electrospraying. J. Appl. Polym. Sci. 2017, 134, 1–9. [Google Scholar] [CrossRef]
- Khoo, R.Z.; Ismail, H.; Chow, W.S. Thermal and Morphological Properties of Poly (Lactic Acid)/Nanocellulose Nanocomposites. Procedia Chem. 2016, 19, 788–794. [Google Scholar] [CrossRef]
- ASTM D882-02; Standard Test Method for Tensile Properties of Thin Plastic Sheeting. ASTM International: West Conshohocken, PA, USA, 2002.
- ASTM E2546-07; Standard Practice for Instrumented Indentation Testing. ASTM International: West Conshohocken, PA, USA, 2015.
- ASTM E96-00; Standard Test Methods for Water Vapor Transmission of Materials. ASTM International: West Conshohocken, PA, USA, 2017.
- ASTM D3985-17; Standard Test Method for Oxygen Gas Transmission Rate Through Plastic Film and Sheeting Using a Coulometric Sensor. ASTM International: West Conshohocken, PA, USA, 2024.
- Silverajah, V.S.G.; Ibrahim, N.A.; Yunus, W.M.Z.W.; Hassan, H.A.; Woei, C.B. A Comparative Study on the Mechanical, Thermal and Morphological Characterization of Poly(lactic acid)/Epoxidized Palm Oil Blend. Int. J. Mol. Sci. 2012, 13, 5878–5898. [Google Scholar] [CrossRef]
- Lu, F.; Yu, H.; Yan, C.; Yao, J. Polylactic acid nanocomposite films with spherical nanocelluloses as efficient nucleation agents: Effects on crystallization, mechanical and thermal properties. RSC Adv. 2016, 6, 46008–46018. [Google Scholar] [CrossRef]
- Popa, E.E.; Rapa, M.; Popa, O.; Mustatea, G.; Popa, V.I.; Mitelut, A.C.; Popa, M.E. Polylactic Acid/Cellulose Fibres Based Composites for Food Packaging Applications. Mater. Plast. 2017, 54, 673–677. [Google Scholar] [CrossRef]
- Asada, M.; Asada, N.; Toyoda, A.; Ando, I.; Kurosu, H. Side-chain structure of poly(methacrylic acid) and its zinc salts in the solid state as studied by high-resolution solid-state 13C NMR spectroscopy. J. Mol. Struct. 1991, 244, 237–248. [Google Scholar] [CrossRef]
- Kumar, V.; Dev, A.; Gupta, A.P. Studies of poly(lactic acid) based calcium carbonate nanocomposites. Compos. Part B Eng. 2014, 56, 184–188. [Google Scholar] [CrossRef]
- Xto, J.; Wetter, R.; Borca, C.N.; Frieh, C.; van Bokhoven, J.A.; Huthwelker, T. Droplet-based in situ X-ray absorption spectroscopy cell for studying crystallization processes at the tender X-ray energy range. RSC Adv. 2019, 9, 34004–34010. [Google Scholar] [CrossRef] [PubMed]
- Cho, D.-Y.; Tappertzhofen, S.; Waser, R.; Valov, I. Chemically-inactive interfaces in thin film Ag/AgI systems for resistive switching memories. Sci. Rep. 2013, 3, 1169. [Google Scholar] [CrossRef] [PubMed]
- Qiao, L.; Zizak, I.; Zaslansky, P.; Ma, Y. The Crystallization Process of Vaterite Microdisc Mesocrystals via Proto-Vaterite Amorphous Calcium Carbonate Characterized by Cryo-X-ray Absorption Spectroscopy. Crystals 2020, 10, 750. [Google Scholar] [CrossRef]
- Singh, V.; Paidi, A.K.; Shim, C.H.; Kim, S.H.; Won, S.O.; Singh, J.P.; Chae, K.H. Calcite Nanocrystals Investigated Using X-ray Absorption Spectroscopy. Crystals 2021, 11, 490. [Google Scholar] [CrossRef]
- Kourmouli, A.; Valenti, M.; van Rijn, E.; Beaumont, H.J.; Kalantzi, O.I.; Schmidt-Ott, A.; Biskos, G. Can disc diffusion susceptibility tests assess the antimicrobial activity of engineered nanoparticles? J. Nanoparticle Res. 2018, 20, 62. [Google Scholar] [CrossRef]
- Parvekar, P.; Palaskar, J.; Metgud, S.; Maria, R.; Dutta, S. The minimum inhibitory concentration (MIC) and minimum bactericidal concentration (MBC) of silver nanoparticles against Staphylococcus aureus. Biomater. Investig. Dent. 2020, 7, 105–109. [Google Scholar] [CrossRef]
- Rijk, R.; Veraart, R. Global Legislation for Food Packaging Materials; WILEY VCH: Ilorin, Nigeria, 2010. [Google Scholar]
- Rapa, M.; Nita, R.N.D.; Vasile, C. Influence of Plasticizers Over Some Physico-chemical Properties of PLA. Mater. Plast. 2017, 54, 73–78. [Google Scholar] [CrossRef]
- Foreman, J.; Gill, P.S.; Sauerbrunn, S.R. Tensile Modulus of Plastic Films; Thermal Analysis & Rheology TA Instruments: New Castle, DE, USA, 1997. [Google Scholar]
- Kervran, M.; Vagner, C.; Cochez, M.; Ponçot, M.; Saeb, M.R.; Vahabi, H. Thermal degradation of polylactic acid (PLA)/polyhydroxybutyrate (PHB) blends: A systematic review. Polym. Degrad. Stab. 2022, 201, 109995. [Google Scholar] [CrossRef]
- Singh, N.B.; Singh, N.P. Formation of CaO from thermal decomposition of calcium carbonate in the presence of carboxylic acids. J. Therm. Anal. Calorim. 2007, 89, 159–162. [Google Scholar] [CrossRef]
- Pandey, A.; Toda, A.; Rastogi, S. Influence of Amorphous Component on Melting of Semicrystalline Polymers. Macromolecules 2011, 44, 8042–8055. [Google Scholar] [CrossRef]
- Lin, Y.; Chen, H.; Chan, C.-M.; Wu, J. Nucleating effect of calcium stearate coated CaCO3 nanoparticles on polypropylene. J. Colloid Interface Sci. 2011, 354, 570–576. [Google Scholar] [CrossRef] [PubMed]
- Sonchaeng, U.; Iñiguez-Franco, F.; Auras, R.; Selke, S.; Rubino, M.; Lim, L.-T. Poly(lactic acid) mass transfer properties. Prog. Polym. Sci. 2018, 86, 85–121. [Google Scholar] [CrossRef]
- Michiels, Y.; Van Puyvelde, P.; Sels, B. Barriers and chemistry in a bottle: Mechanisms in today’s oxygen barriers for tomorrow’s materials. Appl. Sci. 2017, 7, 665. [Google Scholar] [CrossRef]
- Uysal-Unalan, I.; Sogut, E.; Realini, C.E.; Cakmak, H.; Oz, E.; Espinosa, E.; Corredig, M. Bioplastic packaging for fresh meat and fish: Current status and future direction on mitigating food and packaging waste. Trends Food Sci. Technol. 2024, 152, 104660. [Google Scholar] [CrossRef]

| Samples | Elvaloy® PTW (wt%) | CaCO3-Ag Hybrid (wt%) | PLA (wt%) |
|---|---|---|---|
| IMPLA | 5 | 0 | 95 |
| IMPLA2 | 5 | 2 | 93 |
| IMPLA5 | 5 | 5 | 90 |
| IMPLA7 | 5 | 7 | 88 |
| Sample | Scatting Path (Å) | SO2 | DE0 | R-Factor | ||||
|---|---|---|---|---|---|---|---|---|
| Ca-O | Ca-C | Ca-O-C | Ca-O | Ca-Ca | ||||
| N = 6 | N = 6 | N = 12 | N = 6 | N = 6 | ||||
| Calcite | 2.350 | 3.340 | 2.915 | 3.541 | 3.981 | 0.747 | 3.526 | 0.0129 |
| Vaterite | 2.357 | 3.167 | 3.158 | 3.569 | 4.053 | 0.776 | 2.422 | 0.0199 |
| CaCO3-Ag | 2.316 | 2.971 | 3.474 | 3.626 | 4.056 | 0.747 | −1.669 | 0.0115 |
| IMPLA2 | 2.311 | 2.973 | 3.366 | 3.603 | 4.050 | 0.885 | −1.686 | 0.0077 |
| IMPLA5 | 2.314 | 2.951 | 3.291 | 3.612 | 4.047 | 0.898 | −1.877 | 0.0060 |
| IMPLA7 | 2.325 | 2.983 | 3.360 | 3.637 | 4.089 | 0.747 | −0.253 | 0.0081 |
| Sample | MIC (g/mL) | |
|---|---|---|
| Staphylococcus aureus | Escherichia coli | |
| IMPLA2 | 0.267 | 0.133 |
| IMPLA5 | 0.133 | ≤0.067 |
| IMPLA7 | ≤0.067 | ≤0.067 |
| Sample | CaCO3-Ag Content (wt%) | Young’s Modulus (GPa) | Tensile Strength (MPa) | Elongation at Break (%) | Toughness (J/m3) | Reduced Modulus (GPa) | Hardness (GPa) |
|---|---|---|---|---|---|---|---|
| PLA | 0 | 4.67 ± 0.64 | 42.34 ± 6.99 | 2.39 ± 0.65 | 61.90 ± 9.89 | 4.870 ± 0.111 | 0.200 ± 0.009 |
| IMPLA | 0 | 4.25 ± 0.53 | 39.68 ± 4.89 | 4.17 ± 1.62 | 109.11 ± 50.67 | 5.198 ± 0.171 | 0.228 ± 0.010 |
| IMPLA2 | 2 | 5.07 ± 0.38 | 43.65 ± 4.07 | 3.57 ± 0.76 | 98.39 ± 23.04 | 5.096 ± 0.055 | 0.216 ± 0.002 |
| IMPLA5 | 5 | 5.63 ± 1.51 | 48.07 ± 13.81 | 3.77 ± 0.46 | 128.82 ± 36.26 | 5.097 ± 0.038 | 0.212 ± 0.005 |
| IMPLA7 | 7 | 5.32 ± 1.24 | 44.27 ± 9.93 | 4.36 ± 0.76 | 141.98 ± 40.44 | 5.189 ± 0.131 | 0.214 ± 0.008 |
| Sample | Tg (°C) | Tm (°C) | ΔH (J/g) | Crystallinity (Xc,%) | Tmax (°C) | WVTR (g-mm/m2/day) | OTR (cc-mm/m2/day) |
|---|---|---|---|---|---|---|---|
| PLA | 55.3 | 152.2 | 6.63 | 7.1 | 308.7 | 6.08 (±0.09) | 108.23 (±16.34) |
| IMPLA | 55.4 | 150.1 | 19.69 | 22.1 | 330.8 | 6.03 (±0.24) | 151.87 (±13.95) |
| IMPLA2 | 54.9 | 148.9 | 23.92 | 27.5 | 325.1 | 4.36 (±0.18) | 81.68 (±6.82) |
| IMPLA5 | 54.9 | 149.5 | 21.76 | 25.8 | 337.8 | 5.18 (±0.14) | 143.21 (±4.98) |
| IMPLA7 | 53.9 | 149.3 | 23.67 | 28.8 | 350.0 | 6.03 (±0.29) | 155.78 (±4.64) |
Disclaimer/Publisher’s Note: The statements, opinions and data contained in all publications are solely those of the individual author(s) and contributor(s) and not of MDPI and/or the editor(s). MDPI and/or the editor(s) disclaim responsibility for any injury to people or property resulting from any ideas, methods, instructions or products referred to in the content. |
© 2025 by the authors. Licensee MDPI, Basel, Switzerland. This article is an open access article distributed under the terms and conditions of the Creative Commons Attribution (CC BY) license (https://creativecommons.org/licenses/by/4.0/).
Share and Cite
Azarian, M.H.; Yuwawech, K.; Tanthanuch, W.; Junyusen, T.; Wootthikanokkhan, J.; Sutapun, W. Biocompatible, Biodegradable, and Antimicrobial Food Packaging Film from Polylactic Acid and Biogenic Vaterite CaCO3-Ag Hybrid. Polymers 2025, 17, 1345. https://doi.org/10.3390/polym17101345
Azarian MH, Yuwawech K, Tanthanuch W, Junyusen T, Wootthikanokkhan J, Sutapun W. Biocompatible, Biodegradable, and Antimicrobial Food Packaging Film from Polylactic Acid and Biogenic Vaterite CaCO3-Ag Hybrid. Polymers. 2025; 17(10):1345. https://doi.org/10.3390/polym17101345
Chicago/Turabian StyleAzarian, Mohammad Hossein, Kitti Yuwawech, Waraporn Tanthanuch, Tiraporn Junyusen, Jatuphorn Wootthikanokkhan, and Wimonlak Sutapun. 2025. "Biocompatible, Biodegradable, and Antimicrobial Food Packaging Film from Polylactic Acid and Biogenic Vaterite CaCO3-Ag Hybrid" Polymers 17, no. 10: 1345. https://doi.org/10.3390/polym17101345
APA StyleAzarian, M. H., Yuwawech, K., Tanthanuch, W., Junyusen, T., Wootthikanokkhan, J., & Sutapun, W. (2025). Biocompatible, Biodegradable, and Antimicrobial Food Packaging Film from Polylactic Acid and Biogenic Vaterite CaCO3-Ag Hybrid. Polymers, 17(10), 1345. https://doi.org/10.3390/polym17101345










